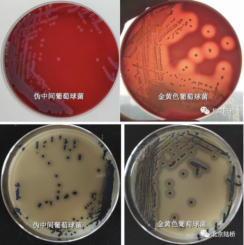

伪中间型葡萄球菌的生化鉴定
葡萄球菌是引起人类感染最常见的致病菌之一,伪中间型葡萄球菌 (Staphylococcus pseudintermedius) 与金黄色葡萄球菌 (Staphylococcus aureus)、表皮葡萄球菌 (Staphylococcus epidermidis) 都属于有临床意义的葡萄球菌。伪中间型葡萄球菌是一种凝固酶阳性葡萄球菌,能够引起犬、猫等动物感染和发病,也有人感染动物源伪中间葡萄球菌的报道。

血浆凝固酶阳性!非金黄色葡萄球菌!与金黄色葡萄球菌的区别在哪里?
选择性分离
在选择性分离阶段,使用Baird-Parker平板和血琼脂平板分别对金黄色葡萄球菌ATCC6538和伪中间型葡萄球菌ATCC49444进行四区划线分离,36℃培养24h。
伪中间葡萄球菌在血琼脂平板上菌落淡灰色、呈露珠状,溶血状态与溶血性葡萄球菌相似,但是溶血迟缓,有的菌株不溶血,而金葡菌落光滑湿润、菌落周围具有清晰明显的β溶血圈。在Baird-Parker平板上,伪中间葡萄球菌菌落呈黑色,菌落周围的浑浊带和透明圈不如金葡明显,在检测过程中也属于可疑葡萄球菌。
血浆凝固酶
凝固酶阳性的葡萄球菌是人类化脓感染中最常见的病原菌,凝固酶阳性葡萄球菌能产生一种游离血浆凝固酶,加速人或兔血浆的凝固,保护病原菌不被吞噬。
血浆凝固酶是鉴别有无致病性的重要指标,也是葡萄球菌鉴定必检的生化项目。能够产生血浆凝固酶的葡萄球菌有:金黄色葡萄球菌(S.aureus),中间葡萄球菌(S.intermedius),海豚葡萄球菌(S.delphini),伪中间型葡萄球菌(S. pseudintermedius) 等8种葡萄球菌。
以ATCC6538金黄色葡萄球菌作为阳性对照,以CMCC26069表皮葡萄球菌作为阴性对照,按照CM304冻干血浆的说明书进行操作,36℃培养,每隔0.5h观察一次,观察6h。结果ATCC6538与ATCC49444呈现凝固,CMCC26069没有凝固。

菌株的故事
根据葡萄球菌属不同种的系统发育树,中间型葡萄球菌、伪中间型葡萄球菌、海豚葡萄球菌三者之间亲缘关系非常近。自1976年中间型葡萄球菌作为一个新种被发表,近30年来一直被认为是动物的条件致病菌。2005年比利时学者根据16SrRNA序列比对和细菌生化鉴定结果,从猫、狗、鹦鹉和马中分离出了伪中间型葡萄球菌。
伪中间型葡萄球菌非常容易与中间型葡萄球菌混杂。根据Sasaki,Bannoehr在2007年的研究结果,17份被鉴定为中间型葡萄球菌的临床样本属于三个不同的种,分别为中间型葡萄球菌,伪中间型葡萄球菌和海豚葡萄球菌。其中所有来自狗,猫和人的细菌都属于伪中间型葡萄球菌。
至此,维持了30年的错误分类被纠正:中间型葡萄球菌一直被认为是动物的主要致病菌,然事实,伪中间型葡萄球菌才是真正的致病元凶。
来源:北京陆桥技术股份有限公司

